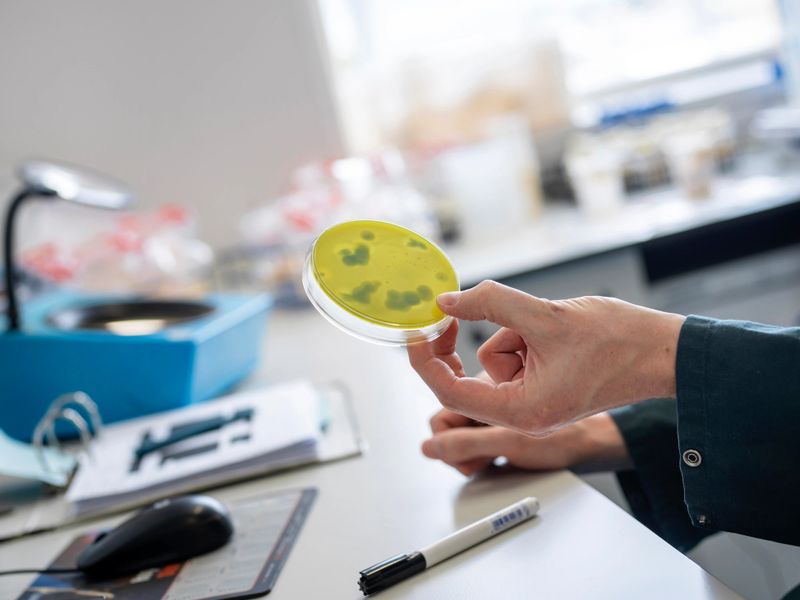
Laboratory technician in dark clothing holding a petri dish with yellow agar medium showing visible bacterial colonies or growth spots. The scientist examines the culture plate in a modern laboratory workspace with equipment and supplies visible in the blurred background. This demonstrates standard microbiological testing procedures for quality control and contamination detection.

About Derby Pharma International: Your Trusted Partner in Global Pharmaceutical Supply

At Derby Pharma International LLC, we are dedicated to facilitating seamless international pharmaceutical partnerships that prioritize reliability and innovation. Founded with the vision to bridge the gap between high-quality pharmaceutical suppliers and healthcare institutions across the globe, we pride ourselves on being a leading London pharmaceutical company committed to delivering exceptional dermatology products and healthcare distribution services in the USA & UK.
Our mission is clear: to provide an efficient supply chain solution that ensures our partners receive the best products, on time, every time. We understand the evolving landscapes of the healthcare market and strive to stay ahead through cutting-edge technologies and strategic collaborations. Our team of experienced professionals is dedicated to fostering trusted relationships, ensuring compliance with international standards, and supporting our partners in their pursuit of excellence in healthcare delivery.
At Derby Pharma, we value integrity, transparency, and innovation. Our clinical approach to operations, combined with our commitment to quality, positions us as a reputable supplier of pharmaceutical products. By focusing on sustainable growth and global partnerships, we aim to contribute to better health outcomes worldwide.